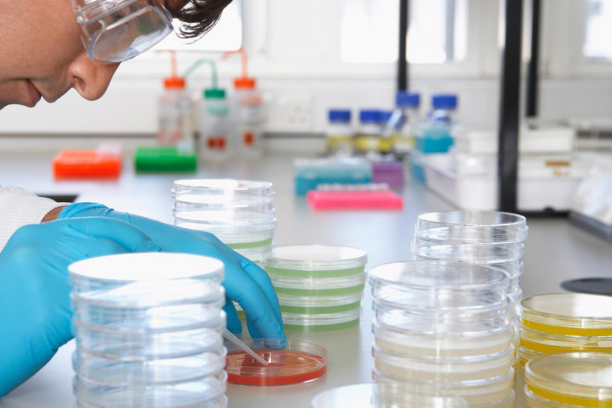

About us
Home - About us
About Us
Redefining Diagnostics with & Care
At 10 MG Diagnostics, we combine accuracy, innovation, and compassion to redefine healthcare diagnostics. Backed by NABL-accredited labs, expert pathologists, and advanced technology, we ensure reliable results with a patient-first approach. From preventive screenings to specialized tests, we make diagnostics simple, accessible, and trustworthy—empowering healthier lives through early detection and informed decisions.
Satisfied Patients
Years of Excellence
Health Plans
Nationwide Reach

- Phone:+1 (859) 254-6589
- Email:info@example.com

- Phone:+1 (859) 254-6589
- Email:info@example.com

- Phone:+1 (859) 254-6589
- Email:info@example.com

- Phone:+1 (859) 254-6589
- Email:info@example.com
Our Services
Trusted Diagnostic Solutions

Pathology Tests

Biochemistry
Serology & Immunology

Microbiology

Histopathology & Cytology

Molecular Diagnostics

Health Packages

Corporate Wellness

Home Sample Collection
Why Choose Us
Why Patients Trust Us
NABL-accredited labs ensure reliable reports for better treatment decisions.
Qualified specialists deliver precise analysis with patient-first diagnostic care.
Qualified specialists deliver precise analysis with patient-first diagnostic care.
Home sample collection and online reports make healthcare hassle-free.





